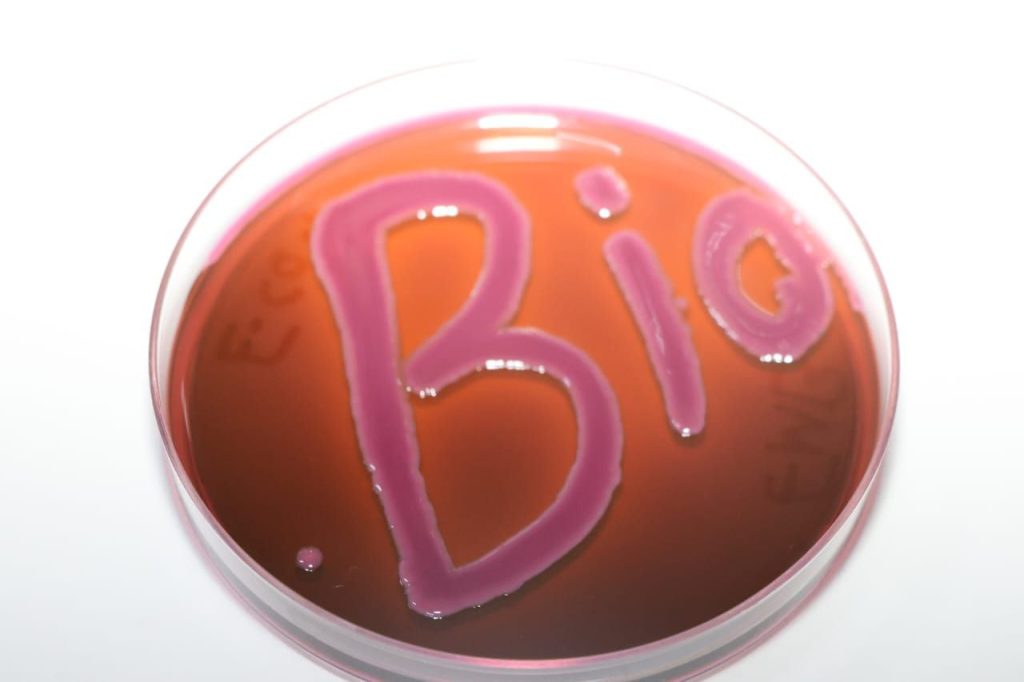
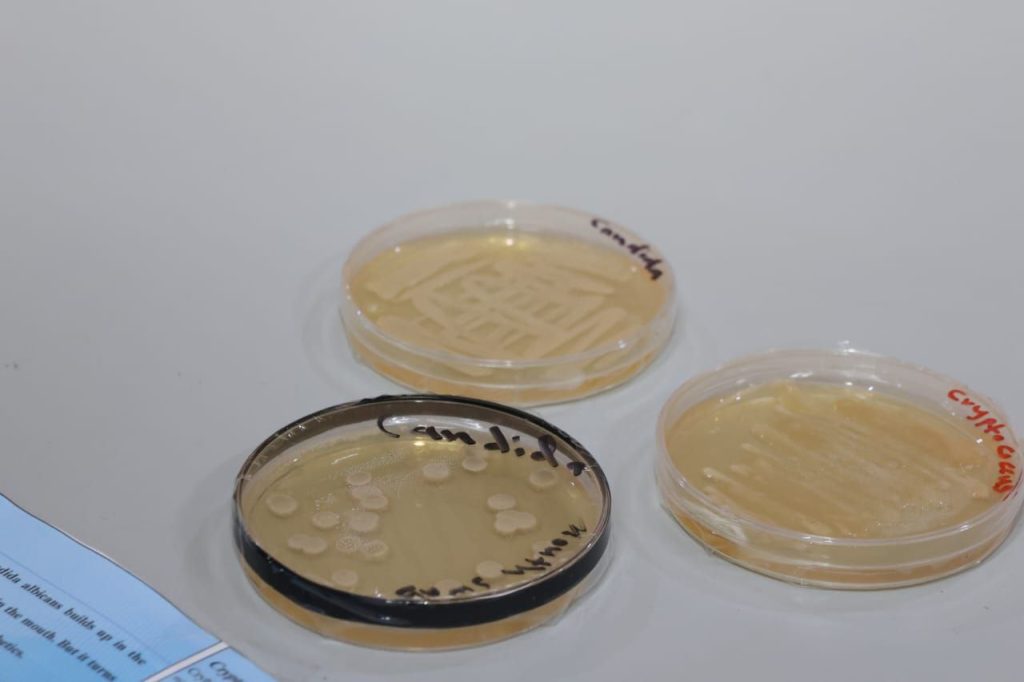

عميد كلية العلوم يفتتح فعاليات أسبوع علوم الحياة في الكلية
برعاية رئيس جامعة ديالى الأستاذ الدكتور تحسين حسين مبارك المحترم، وبإشراف عميد كلية العلوم الأستاذ الدكتور طه محمد حسن المحترم، افتُتحت صباح يوم الاثنين الموافق (2025/10/27) فعاليات أسبوع علوم الحياة للعام الدراسي (2025–2026)، الذي نظمه قسم علوم الحياة في كلية العلوم بجامعة ديالى وبالتعاون مع شعبةالنشاطات الطلابية.استُهلت فعاليات اليوم الأول بجولة افتتاحية لعميد الكلية في أروقة القسم، اطلع خلالها على نشاطات المختبرات العلمية المشاركة في الأسبوع. إذ شهد مختبر الحشرات عرضاً توضيحياً لتنوع الأنواع الحشرية ودورها البيئي والطبي، إلى جانب نماذج مجهرية وملصقات علمية أعدها طلبة المراحل الدراسية.أما مختبر النباتات والفطريات فقد قدّم فعاليات علمية تناولت التنوع النباتي والفطري في البيئة المحلية وأهميته في المحافظة على التوازن البيئي، فضلاً عن عرض عينات وأوساط زراعية استخدمت في الدراسات الميدانية والبحوث التطبيقية.كما تضمنت الفعاليات نشاطات في مختبر الأحياء المجهرية، عرض خلالها الطلبة تجارب عملية حول تشخيص الأنواع البكتيرية والفطرية وطرق التعقيم وفحص العينات تحت المجهر، مما يعكس الجانب العملي التطبيقي لعلوم الحياة في المجال الطبي والبيئي.وأكد الأستاذ الدكتور طه محمد حسن أن هذه الأنشطة تعكس المستوى العلمي المتميز لقسم علوم الحياة، وتهدف إلى ترسيخ المفاهيم البحثية والتطبيقية لدى الطلبة وربط المعرفة النظرية بالواقع العملي.ويأتي تنظيم أسبوع علوم الحياة انسجاماً مع الهدف الرابع من أهداف التنمية المستدامة (التعليم الجيد)، من خلال تنمية مهارات الطلبة في البحث العلمي والتعلم التطبيقي وتحفيز الإبداع في المجالات الحيوية.